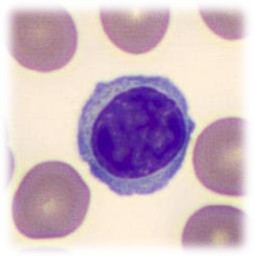

1/11
Without granules
Name | Mastery | Learn | Test | Matching | Spaced | Call with Kai |
|---|
No analytics yet
Send a link to your students to track their progress
Where are the majority of lymphocytes produced?
Produced in the lymphoid tissue
Where are B cells (Lymphocytes) produced?
In the bone marrow
What % of lymphocytes are within the bloodstream?
25%
What is the appearance of a lymphocyte?
Large oval or kidney shaped nucleus, that is stained purple
What are the 3 types of lymphocytes - and out of these 3, which 2 are indistinguishable?
B cells
T cells
Killer cells (slightly larger in size)
B and T cells are indistinguishable
What do B cells produce?
Immunoglobin
What are T cells involved in?
Cell mediated immunity
Killer cells control ..
Control certain cancer cells and microbial infection by limiting their speed
What is a monocyte and where is it produced?
Large immune cell which is produced in the bone marrow
What is the percentage of monocytes within the bloodstream?
5% - for a healthy animal
Appearance of a monocyte ..
Largest of the white blood cells with large purple, bean shaped nucleus

A monocyte is a chronic phagocyte which means it can ..
Smush between cells (like a fried egg)